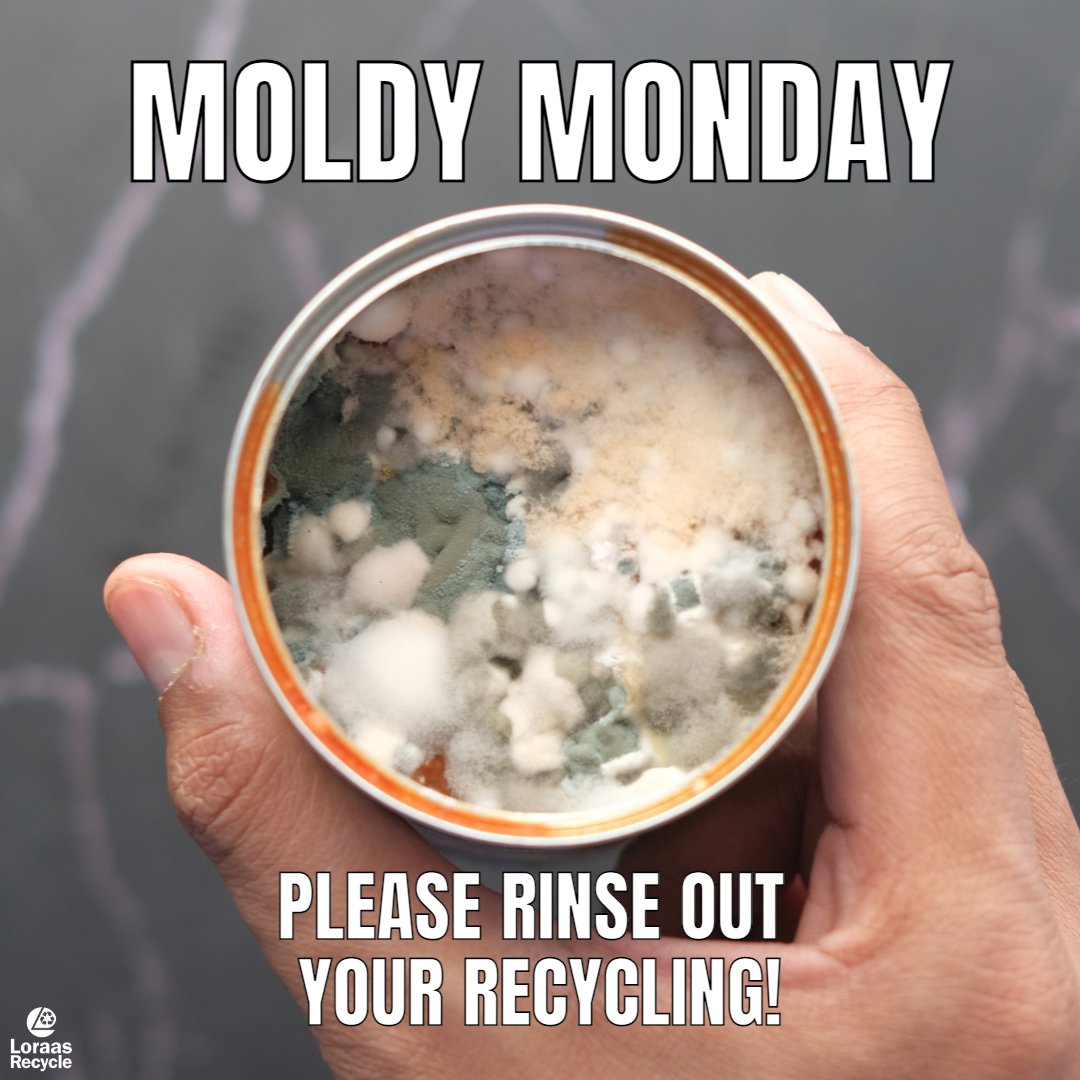
The only thing that should be growing in your blue cart is enthusiasm... 😜

💦Please rinse out your recycling before placing it in your blue cart. When containers mold - it spread to other clean recyclables and ruins them as well.

#mememonday

Loraas Disposal North
@loraasyxe
Your local waste & recycling specialist. Book a free tour! This feed is not monitored 24/7. Q's? DM or call 306-242-2300. Terms of Use: goo.gl/ay6a6v
ID: 953696154901868544
https://www.loraas.ca/ 17-01-2018 18:30:56
1,1K Tweet
413 Takipçi
1,1K Takip Edilen













📢📢REPOST from City of Saskatoon The city-wide Curbside Swap is just around the corner, so if you haven’t already, it’s a great time to start preparing the good ol’ swap pile. ♻️ Learn more at saskatoon.ca/curbsideswap. #CurbsideSwapYXE